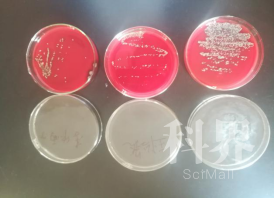

问题分诊室
如何给细菌染色?高中生如何跟博导做科研?—2021年温州市“科技青苗计划”小组活
发布时间: 2021-12-30
活动背景
为贯彻落实《全民科学素质行动计划纲要》要求,深化普通高中课程改革,培养科技创新后备人才,温州市科协、温州市教育局组织实施了“科技青苗计划”,让高中生跟着高校导师做科研。2021年首批青苗计划共聘任5名来自温州医科大学和温州大学的高校导师,立项 5 个项目,共选拔14名分别来自温州中学和瓯海中学的高中学员并建立了高中学科指导团队。
活动团队
“薛向阳导师课题组”团队由温州医科大学博士生导师、基础医学院院长薛向阳教授担任导师,聘任了2名助教,选拔了3名来自温州中学的青苗学员,还确定了2名高中学科指导师。


活动过程
12月18日,“薛向阳导师课题组”团队在温州医科大学如期开展了第一次小组科研活动,研究的课题为《自然环境中和正常人体的细菌分布调查》。
活动1.感受校园科研氛围
课题组团队饶有兴致地走过充满科研氛围的生命大道、院士林及希波拉底桥,参观了癌症疫苗研发科学家周健铜像和生长因子项目、世界青年科学家峰会相关雕塑。


活动2.参观科研创新平台
课题组团队走进生物医药科研楼参观了基础医学院科研协同创新平台,具体有显微镜室、核酸检测室、细胞培养室、高内涵成像室、流式细胞仪室、病毒相关肿瘤研究实验室等科研场所;与实验室教师和研究生交流,了解校院为科研创新所采取的措施和投入,体验科研生活。


活动3.开展细菌学实验研究
三位学员在导师们的指导下本着求实严谨的科学态度和科学合理的实验方法在实验室开展了各种细菌学实验研究。

实验1.细菌分布调查
如何给细菌“做食物”并开展细菌分布调查?学员们通过各种对比实验研究了不同条件下自然环境中及正常人体的细菌分布调查。

实验2.细菌染色实验
如何给细菌染色?学员们重点学习、实践并掌握了革兰氏染色法的原理及操作要领,经过涂片、固定、染色、水洗、干燥、镜检等步骤,染色还包括初染、媒染、脱色、复染四个步骤,每一步都有严格的操作要领,时间需要精确到秒。




活动感想
学员李欣雨:“实验楼内流式细胞仪等‘只应书中观’的设备令我们大开眼界;通过菌落培养、革兰氏染色法及细菌观察,实操与理论结合,我们受益匪浅。”王怡然:“导师们讲解演绎生动,实验操作过程严谨,培养菌落和学习操作革兰氏染色的过程中,更不乏乐趣。”郑匡奇:“希望我也能融于其中,秉持不驰于空想,不骛于虚声的求真精神,继续探索广袤的科学世界。”
本次“科技青苗计划”科研活动,立足于培养创新性人才,实现素质教育多领域动态合作,切实提高高中生的综合素养,从而培养一批科技创新后备人才。

Copyright © 2022 中国科学技术协会 版权所有 | 京ICP备16016202号-20
Copyright © 2022 中国科学技术协会 版权所有 | 京ICP备16016202号-20